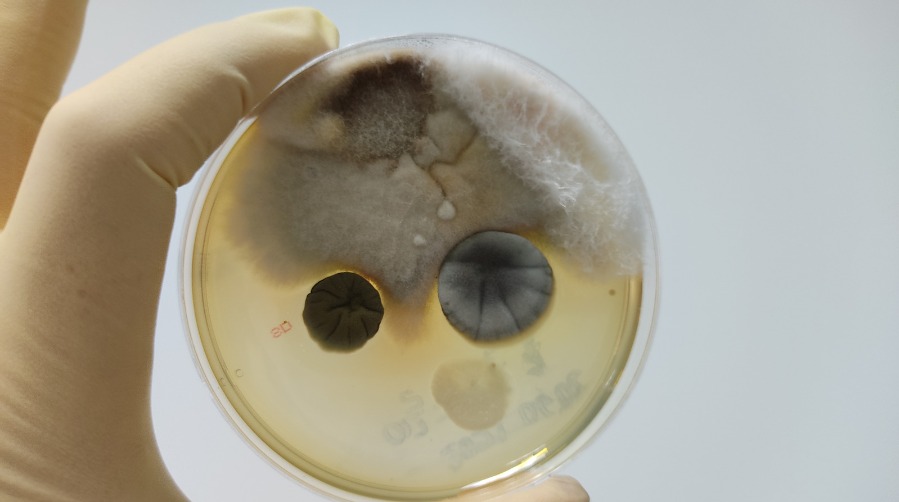

A closer look at mold….
Not every sample is cultured in a petri dish, but laboratory analysis allows us to identify what types of mold are present and how they may be impacting your indoor environment.
By evaluating both the species and concentration, we can determine whether the findings are minimal or indicative of a larger moisture-related concern. That insight helps guide the next steps—whether it’s routine cleaning, targeted repairs, or professional remediation.
Reliable mold testing removes the uncertainty from indoor air quality and provides a clear path forward for a healthier living space.
Call us at 407-753-9463 to schedule your Mold Assessment today!
–
–
–
–
Enviro-Hazard Testing Inc is a woman owned, local mold inspection and testing company proudly servicing the Central Florida area of Mount Dora, The Villages, Orlando, Clermont and more.
#moldtesting #moldremediation #moldillness #mold #airquality #AirQualityMatters #mountdora #eustis #tavares #tricityflorida #lakecounty #floridaliving #clermontfl #TheVillages #hurricaneseason #hurricanemoldinspection #MoldAssessment #HurricaneHelene #HurricaneMilton #flooddamage #orlandomold #orlando #orlandohomes #centralfloridamold #centralfloridahomes






